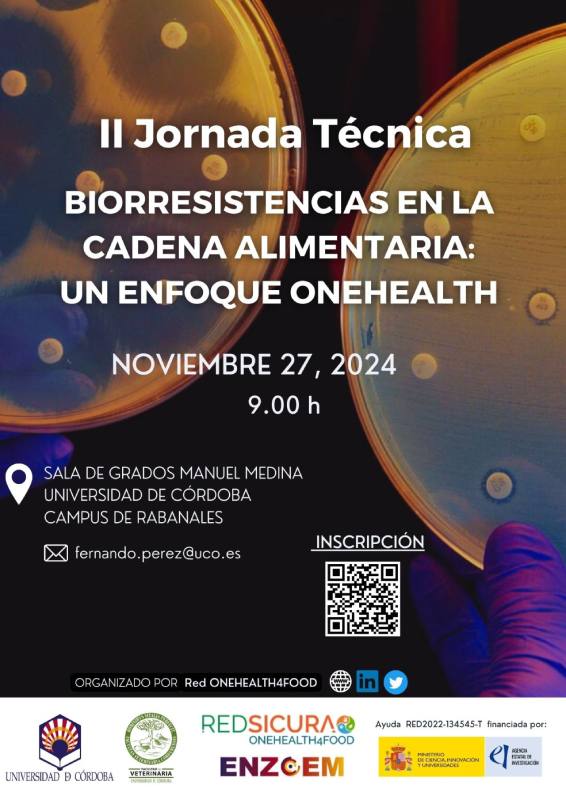

Jornadas y congresos de 2024

II Jornada técnica. Nuevos avances en bioconservación de alimentos.
Fecha: 19 de diciembre de 2024
Lugar: Sala de Grados Manuel Medina, Campus de Rabanales, Córdoba, España
Organiza: Red OneHealth4Food y Grupo HIBRO
II Jornada técnica. Biorresistencias en la cadena alimentaria: Un enfoque OneHealth,
Fecha: 27 de noviembre de 2024
Lugar: Sala de Grados Manuel Medina, Campus de Rabanales, Córdoba, España
Organiza: Red OneHealth4Food y Grupo HIBRO

10th Meeting of the IOBC-WPRS “Integrated Protection of Olive Crops”
Fecha: 11-14 noviembre de 2024
Lugar: Baeza, Spain
Organiza: International Organisation for Biological Control (IOBC)
Juan Moral, miembro del Comité Organizador y Comité Científico.
Más información: webcongreso.com/olive

XLIII Congreso Anaporc
Fecha: 9 y 10 octubre 2024
Lugar: Huesca, España
Organiza: Asociación Nacional de Porcinocultura Científica (ANAPORC)
Francisco José Pallarés, miembro del Comité Organizador y de la Junta Directiva.
Más información: archivo-anaporc.com

XXI Congreso SEF
Fecha: 16-19 de septiembre 2024
Lugar: Palacio de Congresos de Córdoba, Córdoba, España
Organiza: Sociedad Española de Fitopatología.
Juan Moral, miembro del Comité Organizador y Comité Científico.
Más información: sefcordoba2024.com

Listeria monocytogenes: un reto para la seguridad alimentaria
Fecha: 04 de junio de 2024
Lugar: Madrid, España
Organiza: Grupo HIBRO
Más información: uco.es/hibro/es/
